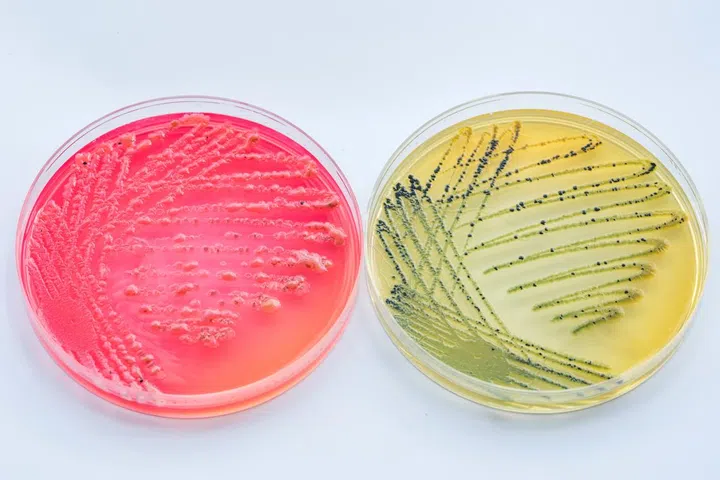

You need to make sure you're well hydrated, so you keep a water glass or cup beside your bed. That’s great: But let’s be honest - the cup or water glass just stays there for days, as you dump out the excess and just keep filling it back up. So how gross is that, really? And how often should you wash your cups, exactly?
You’re probably worried that you’re creating the perfect breeding ground for germs, since microorganisms need a moist environment to survive. And not only that, but then you’re ingesting them, too—so are you really setting yourself up for sickness?
Bacteria can breed
It’s true that bacteria and other potentially dangerous microorganisms (think viruses and intestinal parasites) grow really well in moist environments. So yes, that unwashed cup or water glass can be a petri dish of possibility. Every time you take a sip, you’re transferring the microbes in your mouth to the cup.
“If you’re ill and deposit a nasty bug in that glass and it doesn’t dry properly before you use it again, there might be enough time for that bug to replicate enough to cause your illness again,” says Aaron Margolin, Ph.D., a professor of microbiology at the University of New Hampshire.

Bottled water doesn’t come with chlorine
The source of the water you’re sipping can also make a difference: Unlike tap water, bottled water don’t automatically come with added chlorine to help halt the growth of bacteria.
And your risk grows if you’re sharing the cup with your significant other: All those bacteria, viruses, and intestinal parasites passing back and forth could mean stomach ulcers (courtesy of Helicobacter pylori bacteria) or projectile vomiting and explosive diarrhea (courtesy of norovirus).

Don’t share cups with others
The more people who use that same cup, the greater the probability that one of those people carry bacteria that might make you sick,” warns Margolin. Now, that’s what could happen. But what probably will happen as a result of your unwashed water glass? It’s likely to be a whole lot of nothing, especially if you’re the only one using the glass.
“It’s important to mention that pathogens—those organisms that make you sick—don’t just appear out of nowhere; they have to be introduced by someone or something,” says Margolin.
Glass cups and glasses are better
The fact that it’s a glass, not a plastic cup, means it won’t degrade over time, creating nooks and crannies where bacteria can build up. Plus, glass is more likely to completely dry, and drying, also known as desiccation, is an excellent way to halt the growth of bacteria, adds Margolin.
What’s more, if you’re filling up with tap water, most treatment plants use chlorine to zap dangerous contaminants that work both on the water and your saliva.
Bottom line: “If you restrict the usage of the cup to a single individual and you make sure that the water is clean, then you are not going to get sick if you use the same cup over and over,” says Margolin.
This article was first published on Men's Health.